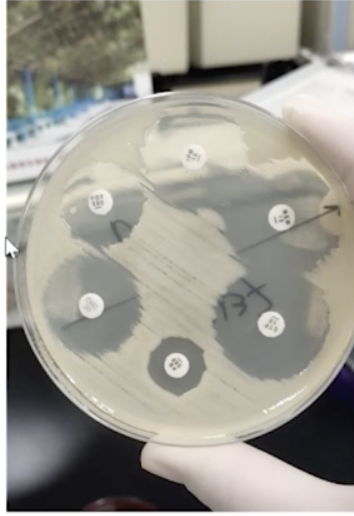
做好这 6 步,搞定儿科细菌感染

最小的细菌

图1 拍摄到迄今世界上最小的细菌体
图片尺寸600x474
科学家合成"最小"细菌 仅有473个基因(图)
图片尺寸500x281
05.13《小细菌,大危险》课程回顾
图片尺寸1094x787
世界上最小的细菌
图片尺寸640x455
图一 皮球?细菌?
图片尺寸640x527
微生物和细菌相比,你觉得哪个最小?为什么?
图片尺寸540x540
病毒非常小,甚至比细菌还小,但数量却比地球上其他生命体的总和还要
图片尺寸950x712
有宝宝的家庭注意了夏季细菌最多有了负离子不再担心宝宝生病
图片尺寸1000x1000
海洋"隐士"里的小巨人 | 少年科学粉_细菌
图片尺寸1080x905
脑筋急转弯:比最小的细菌小的是什么?
图片尺寸448x252
目前发现的最小的细菌(科学家发现肉眼可见的细菌)(7)
图片尺寸640x426
这个是一位小朋友父亲手机的细菌情况.
图片尺寸517x347
世界上最小的细菌体
图片尺寸640x397
10大猎奇细菌饭量最小的细菌--无名海底.
图片尺寸512x407
宝宝身上出现这样的小红点,家长别大意,最好还是去检查_细菌
图片尺寸2000x1333
细菌的大小能相差8个数量级——如果最小的细菌和人的手一样大,拇么
图片尺寸500x281
做好这 6 步,搞定儿科细菌感染
图片尺寸354x516
别喝现挤鲜羊奶了,小心感染致病菌,已有多人入院,最小的才3岁|细菌
图片尺寸640x356
便便上也有小细菌
图片尺寸1792x828
关于细菌的九大事实:离了它们你真的无法存活
图片尺寸550x386